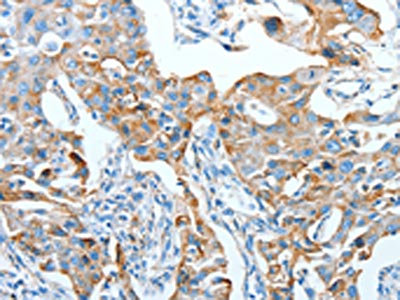

AFAP1 Antibody
-
中文名稱:AFAP1兔多克隆抗體
-
貨號:CSB-PA098902
-
規(guī)格:¥1100
-
圖片:
-
The image on the left is immunohistochemistry of paraffin-embedded Human lung cancer tissue using CSB-PA098902(AFAP1 Antibody) at dilution 1/20, on the right is treated with fusion protein. (Original magnification: ×200)
-
Gel: 8%SDS-PAGE, Lysate: 40 μg, Lane: Human brain malignant glioma tissue, Primary antibody: CSB-PA098902(AFAP1 Antibody) at dilution 1/116, Secondary antibody: Goat anti rabbit IgG at 1/8000 dilution, Exposure time: 1 minute
-
-
其他:
產(chǎn)品詳情
-
Uniprot No.:
-
基因名:AFAP1
-
別名:110 kDa actin filament associated protein antibody; 110 kDa actin filament-associated protein antibody; Actin filament associated protein 1 antibody; Actin filament associated protein 110 kDa antibody; Actin filament-associated protein 1 antibody; AFAP 1 antibody; AFAP 110 antibody; AFAP antibody; AFAP-110 antibody; Afap1 antibody; AFAP1_HUMAN antibody; AFAP110 antibody; FLJ56849 antibody
-
宿主:Rabbit
-
反應(yīng)種屬:Human,Mouse,Rat
-
免疫原:Fusion protein of Human AFAP1
-
免疫原種屬:Homo sapiens (Human)
-
標(biāo)記方式:Non-conjugated
-
抗體亞型:IgG
-
純化方式:Antigen affinity purification
-
濃度:It differs from different batches. Please contact us to confirm it.
-
保存緩沖液:-20°C, pH7.4 PBS, 0.05% NaN3, 40% Glycerol
-
產(chǎn)品提供形式:Liquid
-
應(yīng)用范圍:ELISA,WB,IHC
-
推薦稀釋比:
Application Recommended Dilution ELISA 1:1000-1:2000 WB 1:200-1:1000 IHC 1:15-1:50 -
Protocols:
-
儲存條件:Upon receipt, store at -20°C or -80°C. Avoid repeated freeze.
-
貨期:Basically, we can dispatch the products out in 1-3 working days after receiving your orders. Delivery time maybe differs from different purchasing way or location, please kindly consult your local distributors for specific delivery time.
-
用途:For Research Use Only. Not for use in diagnostic or therapeutic procedures.
相關(guān)產(chǎn)品
靶點詳情
-
功能:Can cross-link actin filaments into both network and bundle structures. May modulate changes in actin filament integrity and induce lamellipodia formation. May function as an adapter molecule that links other proteins, such as SRC and PKC to the actin cytoskeleton. Seems to play a role in the development and progression of prostate adenocarcinoma by regulating cell-matrix adhesions and migration in the cancer cells.
-
基因功能參考文獻:
- The observed up-regulation of AFAP1-AS1 in tumor samples compared with ANCTs implies its involvement in breast cancer pathogenesis and potentiates it as a biomarker or therapeutic target. PMID: 29439313
- The high LncRNA AFAP1-AS1 expression was significantly related to advanced clinical stage, larger tumor size, earlier tumor metastasis, earlier lymph nodal involvement and vascular invasion. High LncRNA AFAP1-AS1 expression was an unfavorable prognostic factor in various cancers. PMID: 29544748
- AFAP-1 is a key mediator in the inflammatory signaling-induced, translocation-independent attenuation of P-glycoprotein efflux in brain capillary endothelial cells. PMID: 28112407
- The genotype frequencies of six SNPs in AFAP1, GMDS and PTGFR genes were conformed to Hardy-Weinberg equilibrium (HWE). PMID: 27862086
- Data indicate three loci associated with primary open-angle glaucoma (POAG) were located upstream of ATP binding cassette transporter 1 (ABCA1), within actin filament associated protein 1 (AFAP1) and within GDP-mannose 46-dehydratase (GMDS). PMID: 25173105
- Methylation of the long noncoding RNA AFAP1-AS1 is reduced in BE and EAC, and its expression inhibits cancer-related biologic functions of EAC cells. PMID: 23333711
- AFAP-110 is required for actin stress fiber formation and cell adhesion in MDA-MB 231 breast cancer cells. PMID: 17520695
顯示更多
收起更多
-
亞細胞定位:Cytoplasm, cytoskeleton, stress fiber.
-
組織特異性:Low expression in normal breast epithelial cell line MCF-10A and in tumorigenic breast cancer cell lines MCF-7, T-47D and ZR-75-1. Highly expressed in the invasive breast cancer cell lines MDA-MB-231 and MDA-MB-435. Overexpressed in prostate carcinoma.
-
數(shù)據(jù)庫鏈接:
Most popular with customers
-
-
YWHAB Recombinant Monoclonal Antibody
Applications: ELISA, WB, IHC, IF, FC
Species Reactivity: Human, Mouse, Rat
-
Phospho-YAP1 (S127) Recombinant Monoclonal Antibody
Applications: ELISA, WB, IHC
Species Reactivity: Human
-
-
-
-
-